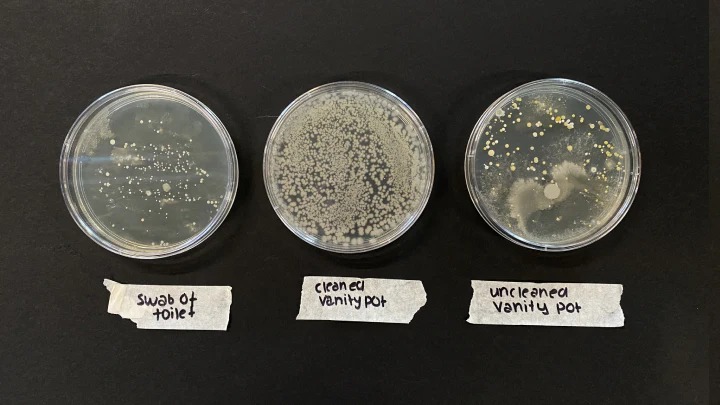

دراسة: البكتيريا المتراكمة على فرش المكياج أكثر من الموجودة بـ مقعد المرحاض
كشفت دراسة جديدة عن وجود كمية مروعة من البكتيريا التي تتراكم على فرش غير مغسولة، موضحة أن البكتيريا المتراكمة على الفرشة أكثر من الموجودة بـ مقعد المرحاض.
مقارنة بـ نتائج مسحة مقعد المرحاض، وجدت الدراسة أنه بصرف النظر عن مكان تخزين الفرشاة، فإن عدد البكتيريا الموجود بفرشة التجميل أو أكثر من المرحاض.
وخلال الدراسة، أجرت إحدى شركات أدوات التجميل استطلاعًا لعملائها، وقال 40٪ منهم إنهم ينظفون فرشهم كل أسبوعين، بينما اعترف 20٪ منهم بغسلها فقط كل شهر إلى ثلاثة أشهر.
وينصح بتخزين فرش المكياج في أماكن مغلقة لتجنب أي بكتيريا أو غبار محمول بالهواء يمكن أن يتجمع، ويجب على مرتدي المكياج غسل شعيرات الفرشاة بـ شامبو لطيف وماء فاتر، ثم يتم تجفيفها بمنشفة نظيفة، ويتم تركها حتى تجف.
فرش المكياج تنقل البكتيريا وخلايا الجلد الميتة والزيوت من وجه إلى منتج
وقالت عالمة التجميل كارلي مصلح، إن فرش المكياج يمكنها نقل البكتيريا وخلايا الجلد الميتة والزيوت من وجه إلى منتج، واستخدام الفرشاة المتسخة بشكل روتيني يمكن أن يؤدي إلى ظهور حب الشباب أو ما هو أسوأ.
وأضافت: استخدام الفرشاة المتسخة يمكن أن يزيد من خطر التسبب في اختلال التوازن في المجتمع الميكروبي الصحي ويؤدي إلى زيادة عدد الميكروبات المسببة للأمراض التي يمكن أن تسبب انتشارًا أو مشاكل أكثر خطورة مثل القوباء أو عدوى المكورات العنقودية، ولتقليل تراكم البكتيريا، من المهم تنظيف فرش المكياج بانتظام.
بينما قالت هانا وصوفي بيكروفت، إحدى المشاركات في الدراسة: نحن جميعًا مذنبون بترك فرش التجميل لفترة طويلة جدًا، مشددة على أهمية تنظيف الفرش مرة واحدة على الأقل في الأسبوع.


